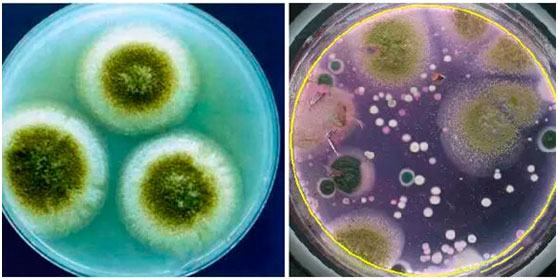

(8月26日 新浪网 原标题:市民网购三七粉服用后不适,专家提醒谨慎购买)
近日,有市民王先生爆料称:其听说保健养生可服用三七粉,于是在网上购买了一包“纯三七粉”,价格相当便宜,才18块一斤。服用之后药效是否起作用不得而知,不过王先生却拉起了肚子。之后王先生找商家协商,商家却说无法证明这与服用他们的商品有关,对此置之不理。

记者在某网购网站上搜索发现,确实有商家在出售超低价的三七粉,并且不止一家,很多都打着“纯三七粉”的口号。但是不是如商家所言,还是挂羊头卖狗肉?带着疑问,我们拿着王先生剩余的包装向医药专家刘医师咨询。
三七粉市场鱼龙混杂,购买要谨慎选择
“目前市场上售卖的三七粉,每500克的价格从三、四百元到一千八、九百元不等,价格过低的不太可能是纯三七粉” 当得知王先生是以18元/斤的价格购买后,刘医师觉得不可思议。刘医师说,因为三七粉已经打成粉,所以普通消费者难辨真假。三七头数(头数指每500克三七中三七的个数)越少说明其单体单体越大、药用含量高、药用效果好,但实际上很多厂家把60头、120头的三七卖出20头、30头的价格,消费者也不得而知。价格较高的尚且不能保证,价格过低的更是不靠谱。
另一方面,以根茎入药的中药材三七在生长过程中根茎常埋于土壤中,上面携带者大量的寄生于土壤中的厌氧菌及因施肥带来的大肠杆菌。虽然采收时进行了简单冲洗,但在药材表皮下还是残留着的大部分细菌。而市售的现磨三七粉在加工过程中大都没有进行灭菌处理,菌群数量极可能严重超标。这样的三七粉,不仅不能治病还会给健康带来危害,消费者应谨慎选择。
(经实验室细菌培养显示:市售现磨三七粉中含有大量致病菌)
三七粉非万能保健品,用药讲究科学配伍
近年来,由于人们养生保健意识的提升,人们越来越关注自身的健康。在国内养生保健领域,三七粉可谓是倍受追捧。很多人认为,三七粉有病治病,无病可以强身,是一种很好的保健品。但刘医师告诉我们,三七是活血化淤中药,因为其有扩血管作用,因此临床上常用来治疗冠心病、心绞痛和脑血栓等,并有一定的降压作用。但其并不算保健品,还有诸多服用禁忌,若使用不当,易耗损津液,造成阴虚之症。而在服用过程中,如果以三七粉单味药食用,治疗效果更难以兼顾各方。中药是以中医理论为基础,有目的地按病情需要和药性特点,有选择地将两味以上药物配合同用,因疾病的发生和发展往往是错综复杂的,中药之间配伍组方应用,才能起到提高疗效、减少毒性的作用。

很多耳熟能详的的中药组方都含有三七,比如云南白药、复方丹参片等。其中复方丹参片由丹参、三七、冰片共同组成,其中丹参祛瘀止痛,活血养血,清心除烦为主药,三七活血通脉,化瘀止痛为辅药,冰片芳香开窍,行气止痛为佐药。诸药相配,药效相辅相成,比单一地食用三七粉效果更好。






















